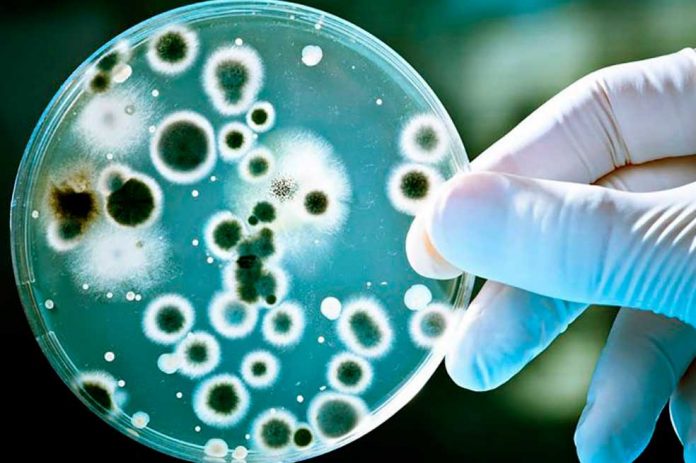
bacteria-usar-4 salud

Fallece inhalador de pegamento en el sector de El Novillo del...
La madrugada de este sábado fue encontrado sin vida un hombre en situación de calle en las afueras de un tramo comercial ubicado en...
Música
Lo que no sabías de “Maldito Corazón”, la herida...
Hay canciones que se escriben para ser escuchadas… y otras para ser sobrevividas.Maldito Corazón, pieza clave en la historia...
Videos
El misterio detrás de la canción viral “Ábreme el cu..”: ¿joya...
En TikTok y otras redes sociales se ha vuelto viral una canción tan curiosa como polémica: “Ábreme el cxlo”. Muchos usuarios creen estar ante...